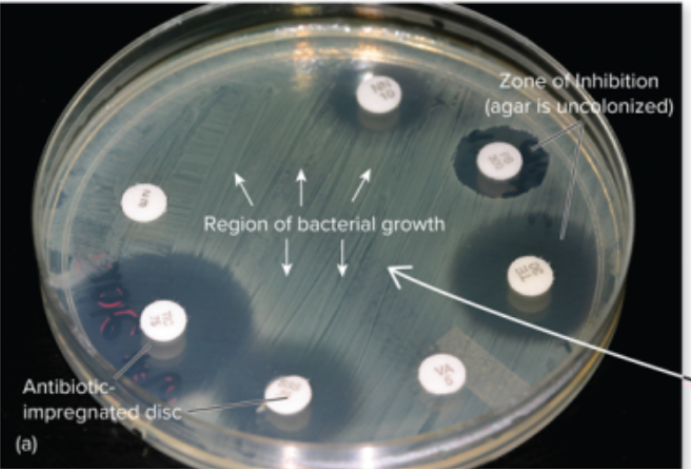
<ul><li><p>An agar plate is inoculated with a <span style="color: yellow;">bacterial </span>lawn,</p></li><li><p>and <span style="color: red;">antibiotic</span>-impregnated paper discs are placed on top</p></li><li><p>the plates are then incubated ;</p></li></ul><p>it measures the "Zone of Inhibition" to determine sensitivity</p>

Set 3: Susceptibility Testing & Therapeutic Index
1/6
There's no tags or description
Looks like no tags are added yet.
Name | Mastery | Learn | Test | Matching | Spaced | Call with Kai |
|---|
No analytics yet
Send a link to your students to track their progress
7 Terms
How is the Kirby-Bauer disk diffusion test performed and what does it measure?
An agar plate is inoculated with a bacterial lawn,
and antibiotic-impregnated paper discs are placed on top
the plates are then incubated ;
it measures the "Zone of Inhibition" to determine sensitivity
What is the definition of the Minimum Inhibitory Concentration (MIC)?
Lowest concentration of antibiotic with no growth; the tube stays clear (no visible growth)
What is the problem with the MIC tube staying clear?
the antibiotic might just be freezing the bacteria in place (bacteriostatic) rather than killing them (bactericidal)
How is the Minimum Lethal Concentration (MLC) determined after an MIC test?
Subculture: You take a sample from the clear tubes (the MIC tube and those with higher concentrations).
Transfer: You put those samples into new containers with fresh media but no antibiotic.
Incubate: You incubate these new containers.
Identify: The MLC is the lowest original concentration where no growth occurs in the new, antibiotic-free container.
Define Toxic Dose and Therapeutic Dose in the context of the Therapeutic Index.
Toxic Dose is the drug level that is too toxic for the host, while Therapeutic Dose is the drug level required for clinical treatment.
Describe the E-test for drug sensitivity
Uses plastic strips with a concentration gradient of an antibiotic to determine sensitivity.
then the strips are placed on agar surface after inoculation of a bacterial lawn with tested strain
What is the "shotgun" approach to therapy and why is it being reduced?
It is the practice of using a broad-spectrum drug before a specific surface/pathogen is identified. It is being reduced because it leads to superinfections and increased antimicrobial resistance.